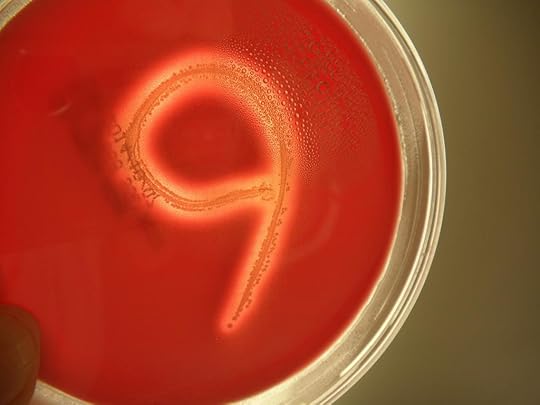
ByZUJMAIEAAvL_2.jpg-large

Michael Marshall's Blog, page 5
October 12, 2014
9 Competition – Week 6 Winner #9ememess #intruders
Well well well.
This week saw a SHOCKING, DISTURBING, MIND-BLOWING (sorry, thought I was a different kind of website there for a moment, about to deliver a dreary list of very average pieces of information loosely centred around pictures of Z-list celebrities that were born without eyebrows) number of entries: 124.
That’s an unholy 87% increase from last week’s 66 — and brings the series total to 379.
Outstanding. Each and every one of you has been given a gold star. But don’t use it as your trigger for the next life, because then you’ll all have the same trigger and that will be confusing. Or maybe just convenient. I don’t know. I haven’t really thought it through. I guess maybe someone could find this out and come up with a dread plan to use a single star to mobilise an entire army of prematurely re-awoken Qui Reverti children, only to be foiled when they get their homework marked… Glen, are you listening? This is good stuff here.
Anyway. This climactic week’s winner was chosen by Millie Brown, who has been so astonishing (hyperbole totally warranted, for once) in the role of Madison/Marcus, in the process scaring the bejesus out of a wide section of the viewing public. She said:
“I’m picking John Montoya. I don’t know why, but it just keeps drawing me in..”
 And you know what? Millie’s absolutely right, but she’s also a tiny bit wrong — personally I would have given it to everybody else, but also John as well. Which is why I was a lousy judge. So, @jomonto, DM me your address and I’ll put you down for a signed copy of the tie-in edition when it arrives. All of the weekly winners will now also be receiving INTRUDERS T-shirts… and I’ll let you know when the books arrive and packages go out.
And you know what? Millie’s absolutely right, but she’s also a tiny bit wrong — personally I would have given it to everybody else, but also John as well. Which is why I was a lousy judge. So, @jomonto, DM me your address and I’ll put you down for a signed copy of the tie-in edition when it arrives. All of the weekly winners will now also be receiving INTRUDERS T-shirts… and I’ll let you know when the books arrive and packages go out.
So now all that’s left is the overall season winner, to be chosen — as I have laboriously and confusingly explained each week — from the entire entry pool. Haven’t got a judge for that yet, so I will announce later in the week… the winner will receive a book, a T-shirt and a copy of the promotional booklet for the series, signed by Mira Sorvino.
Until then, thank you so much all for your 9s — it’s been huge fun doing this, and I’ve had my MIND BLOWN by the quality of entries. Actually, my mind remains unblown, largely because I keep it wrapped in shiny duct tape, but I have genuinely been amazed at the inventiveness and skill and dedication shown. Thank you also to judges Millie Brown, Daryl Shuttleworth and Kristen Cloke, and to Roxie at the BBC for the prizes.
And thank you also for watching the show, assuming you’ve been able to… If not, it’s coming soon. Honestly.
And don’t you be a stranger. You know where I am. The end is not the end.
What goes around comes around.
Until then, be loud.
9 Competition - Week 6 Winner #9ememess #intruders
Well well well.
This week saw a SHOCKING, DISTURBING, MIND-BLOWING (sorry, thought I was a different kind of website there for a moment, about to deliver a dreary list of very average pieces of information loosely centred around pictures of Z-list celebrities that were born without eyebrows) number of entries: 124.
That's an unholy 87% increase from last week's 66 — and brings the series total to 379.
Outstanding. Each and every one of you has been given a gold star. But don't use it as your trigger for the next life, because then you'll all have the same trigger and that will be confusing. Or maybe just convenient. I don't know. I haven't really thought it through. I guess maybe someone could find this out and come up with a dread plan to use a single star to mobilise an entire army of prematurely re-awoken Qui Reverti children, only to be foiled when they get their homework marked... Glen, are you listening? This is good stuff here.
Anyway. This climactic week's winner was chosen by Millie Brown, who has been so astonishing (hyperbole totally warranted, for once) in the role of Madison/Marcus, in the process scaring the bejesus out of a wide section of the viewing public. She said:
"I'm picking John Montoya. I don't know why, but it just keeps drawing me in.."
 And you know what? Millie's absolutely right, but she's also a tiny bit wrong — personally I would have given it to everybody else, but also John as well. Which is why I was a lousy judge. So, @jomonto, DM me your address and I'll put you down for a signed copy of the tie-in edition when it arrives. All of the weekly winners will now also be receiving INTRUDERS T-shirts... and I'll let you know when the books arrive and packages go out.
And you know what? Millie's absolutely right, but she's also a tiny bit wrong — personally I would have given it to everybody else, but also John as well. Which is why I was a lousy judge. So, @jomonto, DM me your address and I'll put you down for a signed copy of the tie-in edition when it arrives. All of the weekly winners will now also be receiving INTRUDERS T-shirts... and I'll let you know when the books arrive and packages go out.
So now all that's left is the overall season winner, to be chosen — as I have laboriously and confusingly explained each week — from the entire entry pool. Haven't got a judge for that yet, so I will announce later in the week... the winner will receive a book, a T-shirt and a copy of the promotional booklet for the series, signed by Mira Sorvino.
Until then, thank you so much all for your 9s — it's been huge fun doing this, and I've had my MIND BLOWN by the quality of entries. Actually, my mind remains unblown, largely because I keep it wrapped in shiny duct tape, but I have genuinely been amazed at the inventiveness and skill and dedication shown. Thank you also to judges Millie Brown, Daryl Shuttleworth and Kristen Cloke, and to Roxie at the BBC for the prizes.
And thank you also for watching the show, assuming you've been able to... If not, it's coming soon. Honestly.
And don't you be a stranger. You know where I am. The end is not the end.
What goes around comes around.
Until then, be loud.
October 5, 2014
9 Competition – Week 5 Winner #9ememess #intruders
I know what you’re thinking.
No, actually, I know what you’re thinking.
And some of you need help.
Quite urgently.
But I know that you’re mainly thinking it’s high time to be told the results of the 5th and penultimate #9ememess competition. By a happy co-incidence, that’s what I’m here to reveal. Okay, it’s not a co-incidence.
Numbers first, as always. There were a whopping 66 entries, which represents not only a 62% increase on last week’s tally, but is the highest so far by some margin. Am I pleased? Well, do I look pleased? Actually, yes, I do. This is my “pleased” face. It happens to closely resemble my “who the fuck are you?” face and my “the world is an endless tunnel of suffering and despair” face and even my “is that my triple-shot two-pump mocha-tall-chino without whip?” face, but I can’t help that. I have now officially called off the meteor strike. You may rest easy.
All the entries are here. Judging this week was @D_Shuttleworth, aka Det. Blanchard in INTRUDERS, who said… “I like this one: Seems to evoke the underworld feel of the shepherds and Qui Reverti.”
So, @yerack, DM me your address and as soon as the Harper tie-in book is in my hands (and they’re working on cover art now, so it shouldn’t too long), I’ll sign a copy of it to you or anyone else you choose, and convey it to you by means of a logistics enterprise under the auspices of the US government that specializes in the transportation of physical objects from one place to another, sometimes without mishap.
Remember, as always, that after this next week’s contest, there will be a final über-competition where every single picture entered over the entire run will be back in contention. Don’t know who’s going to be judging that yet. I asked God, but she declined, saying she’s “behind on a bunch of shit already and none of you assholes even believe in me any more so what’s the frikkin’ point?” She sounded a bit overwrought, to be honest.
And now… yes. It’s the last and final and ultimate week of the competition, the judge for which is currently under negotiation. I’ll let you know asap. And do I really have to tell you that it would be awesome if we could out-do ourselves here both with the sheer quality and number of entries? This is the last week of the nines, people — time to step up and go nuts. Or nut up and go steps. I’m even going to abandon the quantity restriction – you can put in as many entries as you like… but do try to give us your best shot/s.
Rules, as always, are here.
Nine me.
9 Competition - Week 5 Winner #9ememess #intruders
I know what you're thinking.No, actually, I know what you're thinking.
And some of you need help.
Quite urgently.
But I know that you're mainly thinking it's high time to be told the results of the 5th and penultimate #9ememess competition. By a happy co-incidence, that's what I'm here to reveal. Okay, it's not a co-incidence.
Numbers first, as always. There were a whopping 66 entries, which represents not only a 62% increase on last week's tally, but is the highest so far by some margin. Am I pleased? Well, do I look pleased? Actually, yes, I do. This is my "pleased" face. It happens to closely resemble my "who the fuck are you?" face and my "the world is an endless tunnel of suffering and despair" face and even my "is that my triple-shot two-pump mocha-tall-chino without whip?" face, but I can't help that. I have now officially called off the meteor strike. You may rest easy.
All the entries are here. Judging this week was @D_Shuttleworth, aka Det. Blanchard in INTRUDERS, who said... "I like this one: Seems to evoke the underworld feel of the shepherds and Qui Reverti."
So, @yerack, DM me your address and as soon as the Harper tie-in book is in my hands (and they're working on cover art now, so it shouldn't too long), I'll sign a copy of it to you or anyone else you choose, and convey it to you by means of a logistics enterprise under the auspices of the US government that specializes in the transportation of physical objects from one place to another, sometimes without mishap.
Remember, as always, that after this next week's contest, there will be a final über-competition where every single picture entered over the entire run will be back in contention. Don't know who's going to be judging that yet. I asked God, but she declined, saying she's "behind on a bunch of shit already and none of you assholes even believe in me any more so what's the frikkin' point?" She sounded a bit overwrought, to be honest.
And now... yes. It's the last and final and ultimate week of the competition, which will be judged by Millie Brown, the extraordinary young actress who plays Madison. I'll let you know asap. And do I really have to tell you that it would be awesome if we could out-do ourselves here both with the sheer quality and number of entries? This is the last week of the nines, people — time to step up and go nuts. Or nut up and go steps. I'm even going to abandon the quantity restriction - you can put in as many entries as you like... but do try to give us your best shot/s.
Rules, as always, are here.
Nine me.
September 28, 2014
9 Competition – Week 4 Winner #9ememess #intruders
Put down what you’re doing. It’s time for some results.
So we didn’t quite hit our numerical target — there were 41 entries last week, against 53 the week before — but the range, inventiveness and sheer art of the 9s entered leapt again, and was so disturbingly high that I’m calling it a win. I hadn’t really managed to divert the meteor collision yet anyway. Working on it.
I would have found it so hard to pick a winner that I’m relieved (I just mis-typed that as “relived”, which is ominous…) that judging this week was performed by series co-writer Kristen Cloke Morgan, whose episode last night left people quivering silently and deciding that yes, maybe another glass of wine is a good idea, and what’s wrong with grown-ups using night-lights anyway. She said…
“I think this is the one, as my step-son is studying microbiology in college & I love the idea of science and science fiction meeting in the “9 Room”.
And that, for the few out there who didn’t spot it right away, is a bunch of Streptococcus bacteria devouring a dish of blood. It’s new on the menu at KFC*. There are two other equally creepy custom-made microbial images — and lots of other great 9s — on the competition page here.
So @edge_of_the_map and @BigD1980, please DM me your information, and I’ll put you both down for a tie-in copy of INTRUDERS, signed to whomsoever you choose, when it becomes available. There are other goodies on their way from BBC America, which I will disperse according to whim and in as unfair a way as possible.
And now… we’re into the penultimate week of this competition, ending next Saturday, the 5th. You know what that means. Actually, maybe you don’t. Maybe I don’t. But start sending in new 9s, is my point. Our target this week is “lots”. If we fail, I will give Madison your address and a rusty scalpel.
The rules, as always, are here. And do I have to remind you to pass this on and RT?
I really hope not.
* This remark was deployed for humorous purposes, and is not intended to allege or imply any shortfall in either food quality or standards of hygiene. Personally, I love me some KFC. Feel free to send a bucket, right now. And again tomorrow. Until further notice.
9 Competition - Week 4 Winner #9ememess #intruders
Put down what you're doing. It's time for some results.
So we didn't quite hit our numerical target — there were 41 entries last week, against 53 the week before — but the range, inventiveness and sheer art of the 9s entered leapt again, and was so disturbingly high that I'm calling it a win. I hadn't really managed to divert the meteor collision yet anyway. Working on it.
I would have found it so hard to pick a winner that I'm relieved (I just mis-typed that as "relived", which is ominous...) that judging this week was performed by series co-writer Kristen Cloke Morgan, whose episode last night left people quivering silently and deciding that yes, maybe another glass of wine is a good idea, and what's wrong with grown-ups using night-lights anyway. She said...
"I think this is the one, as my step-son is studying microbiology in college & I love the idea of science and science fiction meeting in the "9 Room".
And that, for the few out there who didn't spot it right away, is a bunch of Streptococcus bacteria devouring a dish of blood. It's new on the menu at KFC*. There are two other equally creepy custom-made microbial images — and lots of other great 9s — on the competition page here.
So @edge_of_the_map and @BigD1980, please DM me your information, and I'll put you both down for a tie-in copy of INTRUDERS, signed to whomsoever you choose, when it becomes available. There are other goodies on their way from BBC America, which I will disperse according to whim and in as unfair a way as possible.
And now... we're into the penultimate week of this competition, ending next Saturday, the 5th. You know what that means. Actually, maybe you don't. Maybe I don't. But start sending in new 9s, is my point. Our target this week is "lots". If we fail, I will give Madison your address and a rusty scalpel.
The rules, as always, are here. And do I have to remind you to pass this on and RT?
I really hope not.
* This remark was deployed for humorous purposes, and is not intended to allege or imply any shortfall in either food quality or standards of hygiene. Personally, I love me some KFC. Feel free to send a bucket, right now. And again tomorrow. Until further notice.
September 25, 2014
9 Competition – Week 3 Winner #9ememess #intruders
And lo, it’s time to announce the winner of the third weekly #9ememess competition… Actually, I know, it’s well past time. Technical difficulties prevented it from coming out both when it was supposed to, and with the steady hand of Mira guiding the helm.
There were 53 entries in that week of Sept 14-20th. This represented a 6% increase on the week before, which — while not as heart-warming as the previous gain — means that almost none of you will turn up to your desks tomorrow to find a cardboard box to put all your crap in, with the words “It has been decided that your career would be most positively conducted within the confines of some other company” scrawled on it with a force that speaks not only of great finality, but near-murderous rage.
The standard in the third week was bewilderingly, terrifyingly high… which is why I’d been intending that someone else would pull the trigger. I started making a list of all the ones I especially liked and then stopped when I realized it included all of them.
I had to pick a single winner — had to, you understand that, I hope. And so it’s…
So there we go: @eyglo, please DM me your address, and as soon as the tie-in books arrive, one will be on its way to you, signed to whomever you choose.
All of the entries to the competition so far can be viewed here. To everyone who didn’t win, I’d just like to say that — while I stand behind my choice, naturally — I’m, like, totally wrong, and you should have won instead.
Take heart, as always, from my quixotic and difficult-to-articulate declaration that the overall competition winner will be chosen from all entries over the six weeks, not just the six weekly winners. Huh — actually that sounds less confusing than usual.
Now it’s well past time to start submitting entries for the 4th week’s competition, which I’m delighted to confirm will be judged by Kristen Cloke Morgan… [@kristenclokem] who co-wrote the episode showing this Saturday night. You have until midnight PDT this Saturday to get new entries in… that’s like, two days.
As always, please retweet and pass along… the rules are here. If we get more than 53 entries — which is going to need some speedy work from people, so crack on with it — then I’ve arranged it so that a meteor due to hit the planet in the year 2167 will narrowly miss us instead.
If we don’t, well…
September 14, 2014
9 Competition – Week 2 Winner… #9ememess #intruders
Well, blimey — as we (occasionally, and often ironically) say in the UK. Not only has the number of entries increased — to 50, representing a 35% increase in productivity week-on-week: well done everyone, you can expect a tiny financial bonus at Christmas, and I’ll undertake to refill the water cooler on a slightly more regular basis — but the range and quality is up too. There were at least ten or twelve pictures that could have won…
So hard was it to choose, in fact, that next week I’m going to give myself a break from the intense psychological vortex of considering #9 before it lands me in a padded cell, and hand the challenge over to a guest judge… Mira Sorvino.
In the meantime, check out the entries…
See what I’m saying? The sheer scariness of @wcuebas’s nines-in-the-eyes picture… the thematic consistency of @ljoneill670’s birthday candle… the meta-ness of @yerackfotos using all the Instagram settings set to +/-9… the customary classiness of @eyglo’s entry… the “that must have been quite tiring”-ness of @stufromb’s grass 9, or the “having nine of my books in chronological order”-ness of @pajone’s entry… so many of the others… gah.
I had to pick just one, godammit. And in the end, I’ve gone for @MrAndyFox‘s noirish and Richard Shepherdy picture below… which looks like it could be a still from the show.
A copy of the tie-in will be coming your way as soon as it’s available, signed to whomever you choose. Please DM me your email address…
But remember, everybody: not winning this week doesn’t mean the picture’s not still in with a chance of the overall competition. (I’ve got to find a better way of saying that).
Next week’s competition starts… NOW. So enter up to three pictures over the coming week, for the chance to be judged by Mira… she seems nice, though. I’m sure she won’t judge you harshly. Not as harshly as I would, certainly.
The rules are here. Most important is the one about including the #9ememess hashtag in your tweet, to ensure your picture/s come to the judges’ attention… It’s good to have the #intruders tag there too. Please RT and pass around… the more entries the better. Tell people to find the nines…
Our target is to beat 50 pictures this week, or upcoming staff assessments will be brutal.
Possibly even fatal.
September 7, 2014
9 Competition – Week 1 Winner #9ememess #intruders
After a week spent thinking more about #9 than is probably seemly, it’s time for me to announce the first winner of the competition (original post and rules are here). Just so you know, I’m listening to the 9th Goldberg Variation (Mia Chung, 2006) while I type this, and the post will go up at 6:03pm. I’m not messing about with this shit.
There were 34 entries during the first week, and I love each and every one of them. Choosing a winner was tough: so hard, in fact, that I’m adding a new rule, thus:
10: The overall season winner will be chosen from all entries over the six weeks, not just from the winners of the six weekly contests.
Not having won in any given week, therefore, doesn’t mean you’re not still in with a chance at the overall title. Is that enough negatives in one sentence? Yes, I think it is.
This gives me the freedom to decide that in fact, something submitted in week 1, 2 or 6 that didn’t win its week does however sum up the entire competition in some ineffable way, and deserves the grand prize. I’m aware this rule doesn’t seem very logical, but it’s my competition, and I believe the hallmark of any aspiring despot should be a dark thread of unreason.
And the first winner is… @wcuebas. For not only finding a 9, but being one.
So, @wcuebas… DM me your email address via Twitter, and I’ll put you down for a signed tie-in copy of THE INTRUDERS as soon as it’s published by HarperCollins.
And now… start finding and putting up entries for week 2’s competition, and again, please RT and pass this message around (and the rules). The more entries we receive, the better the prizes. I’m told that INTRUDERS-related goodies will be coming my way soon from BBC America, so who knows that next week’s astonishing reward might be…
Here are this week’s entries… hover over the thumbnail to see the Twitter name of the poster (with underscore and entry number appended, where applicable), and click on it to see the full image.
August 30, 2014
The 9 competition… #intruders #9ememess
Tonight will see the second episode of INTRUDERS, on BBCA in the US. [No, we still don't know when it'll be shown in the UK. Soon as I know, so shall you.]
In the run-up to the premiere I had #9 on the brain, and took to tweeting a different 9 picture every day. And you know what? It was fun. Yes, I should doubtless get out more. A lot more. So should you. In fact, stop reading this and go for a walk. I’ll wait.
Back? Good. My brain’s about as full of 9 as it’s healthy to be, so now I’m handing on The Joy of 9 to you. During each week of the six episodes remaining after tonight, I urge you to seek out — or create — 9s, and photograph them. Extra credit will be given for unusual beauty, hugeness, ugliness, extraordinariness, tininess, mundanity, spookiness, inventiveness…
Please read all of the following very carefully:
Inadequate Rules:
1. A maximum of three entries per week per person. Give us your best shot/s.
2. Only enter a given image once, please. Not week after week.
3. Don’t tweet the pictures direct @ me, but to the world at large…
4. … and all entries need to be hashtagged with both #intruders and #9ememess [otherwise they won't be seen]. You can start putting them up from now… for the first judging, next weekend.
5. You’ll need to follow me on Twitter, too, so I can DM each week’s winner. Don’t fret, you can unfollow again afterwards. Be like that. See if I care. No, seriously. In your face.
6. Closing time each week is midnight PST on Saturday. Each week’s winner will be announced by midnight PST the next day (Sunday).
7. No purchase necessary, except in places where it is. Though if you’d like to purchase me a pint at some point, you’ll hear little argument. And no, INTRUDERS doesn’t have to be currently viewable in your country or territory or house for you to enter.
8. The 9 needs to be created or at least photographed by you. Don’t be stealing other people’s images. That’s so not cool.
9. I’m sure there’s a bunch of gnarly T&Cs I’ve failed to think of, but you get the idea. Don’t give me grief. I don’t make the rules. Okay, on this occasion, I actually have made the rules. It makes me realize how hard making the rules is. Let’s spare a thought for the rule-makers. They’re people too. Apart from whoever made up that one about how your hair always suddenly looks a bit less crap on the day you’ve got a haircut booked. That’s just annoying.
Every week a winner will at the very least receive a copy of the HarperCollins tie-in edition of THE INTRUDERS (when it becomes available later in the year), signed to whomever you wish, in any manner short of libel. Yes, you can win more than one week’s competition… in which case, we’ll talk about further prizes.
An overall victor — the best 9 in the entire season — will receive something even more awesome. I’m not sure what yet, but rest assured: it shall be spoken of in legend and song. I will liaise with the cast, crew and production supremos, and see what we can come up with.
Please RT and pass this on. I appreciate that doing so marginally decreases the chances of you winning, but it will also hopefully save me from admitting there’s only two entries each week, both submitted by me under false names, and I don’t like either of them. And you don’t want me to feel that way, do you? Do you really want to make me sad? I hope not.
Plus — the more people who enter, the cooler the all-season prize is likely to be…
So… The stolid 9 of a neighbour’s mailbox, or on a Safeway price sticker. The eroded remains of an elegant 9 traced in the sand. Nine breakfast burritos arranged to look a bit like Stonehenge. A still image of a mime artist successfully evoking Beethoven’s choral symphony while nine arcs of lightning briefly touch the ground around them. (Hint — if you can pull that off, you’re in with a good chance of winning). An improbably vast 9 on the far side of the moon, a thousand miles wide, made out of leftover ballerinas.
However the urge takes you.
This is our life. Not theirs. And these are our nines.
Michael Marshall's Blog
- Michael Marshall's profile
- 413 followers